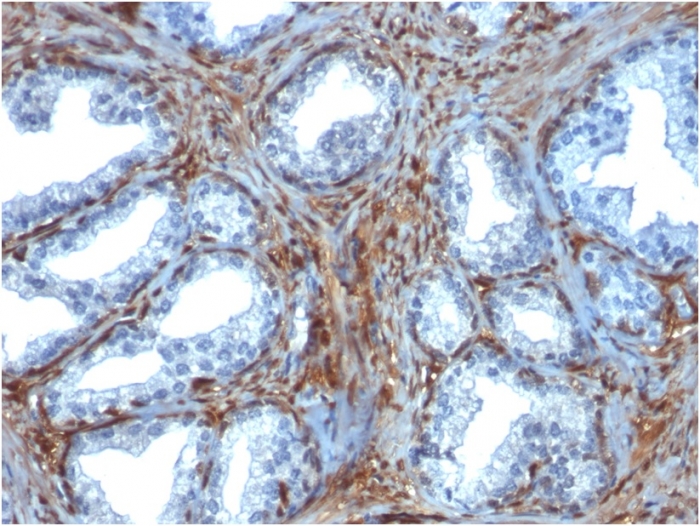
Formalin-fixed, paraffin-embedded human Prostate Carcinoma stained with Galectin-1 Monospecific Mouse Monoclonal Antibody (GAL1/1831). Galectin-1 / Human Placental Lactogen (hPL) Antibody

Formalin-fixed, paraffin-embedded human Prostate Carcinoma stained with Galectin-1 Monospecific Mouse Monoclonal Antibody (GAL1/1831).

Western Blot of HeLa, K562 and 293 cell lysates Galectin-1 Monospecific Mouse Monoclonal Antibody (GAL1/1831).

Western Blot Analysis of HeLa cell lysate using Galectin-1 Monospecific Mouse Monoclonal Antibody (GAL1/1831).

Confocal immunofluorescence image of HeLa cells using Galectin-1 Monospecific Mouse Monoclonal Antibody (GAL1/1831). Green (CF488) and Reddot is used to label the nuclei Red.

SDS-PAGE Analysis Purified Galectin-1 Monospecific Mouse Monoclonal Antibody (GAL1/1831). Confirmation of Integrity and Purity of Antibody.

Analysis of Protein Array containing more than 19,000 full-length human proteins using Galectin-1 Monospecific Mouse Monoclonal Antibody (GAL1/1831). Z- and S- Score: The Z-score represents the strength of a signal that a monoclonal antibody (MAb) (in combination with a fluorescently-tagged anti-IgG secondary antibody) produces when binding to a particular protein on the HuProtTM array. Z-scores are described in units of standard deviations (SD's) above the mean value of all signals generated on that array. If targets on HuProtTM are arranged in descending order of the Z-score, the S-score is the difference (also in units of SD's) between the Z-score. S-score therefore represents the relative target specificity of a MAb to its intended target. A MAb is considered to specific to its intended target, if the MAb has an S-score of at least 2.5. For example, if a MAb binds to protein X with a Z-score of 43 and to protein Y with a Z-score of 14, then the S-score for the binding of that MAb to protein X is equal to 29.
Galectin-1 is a member of the beta-galactoside-binding family and is a dimeric protein of 14kD participating in a variety of normal and pathological processes, including cancer progression. Galectin-1 can affect the proliferation of normal and malignant cells. Inhibition of cell growth is observed in a lactose-dependent manner as lower concentrations of the lectin stimulate cell proliferation. Galectin-1 may also be implicated in the induction of apoptosis of activated T cells through the binding of exogenous galectin-1 to CD45 molecules present on the surface of lymphocytes. Galectin-1, reported to be present either at the surface of cancer cells or accumulated around these cells could act as an immunological shield to protect against a T cell immune response and provide an advantage for survival.
There are no reviews yet.